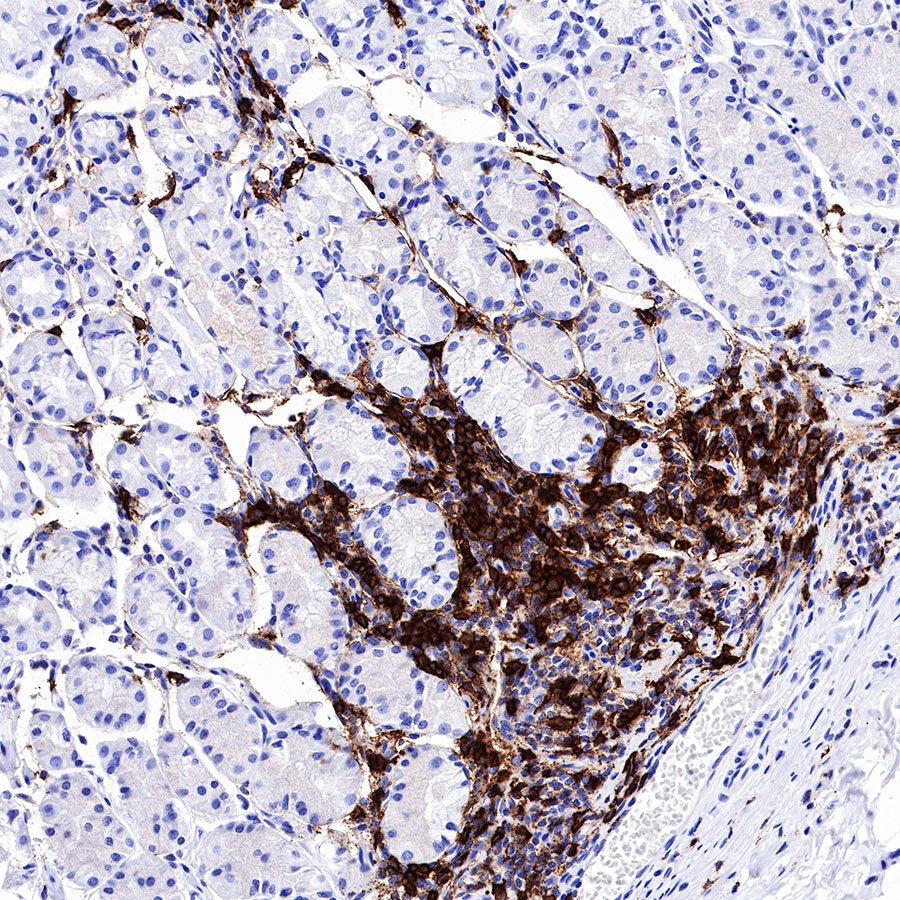
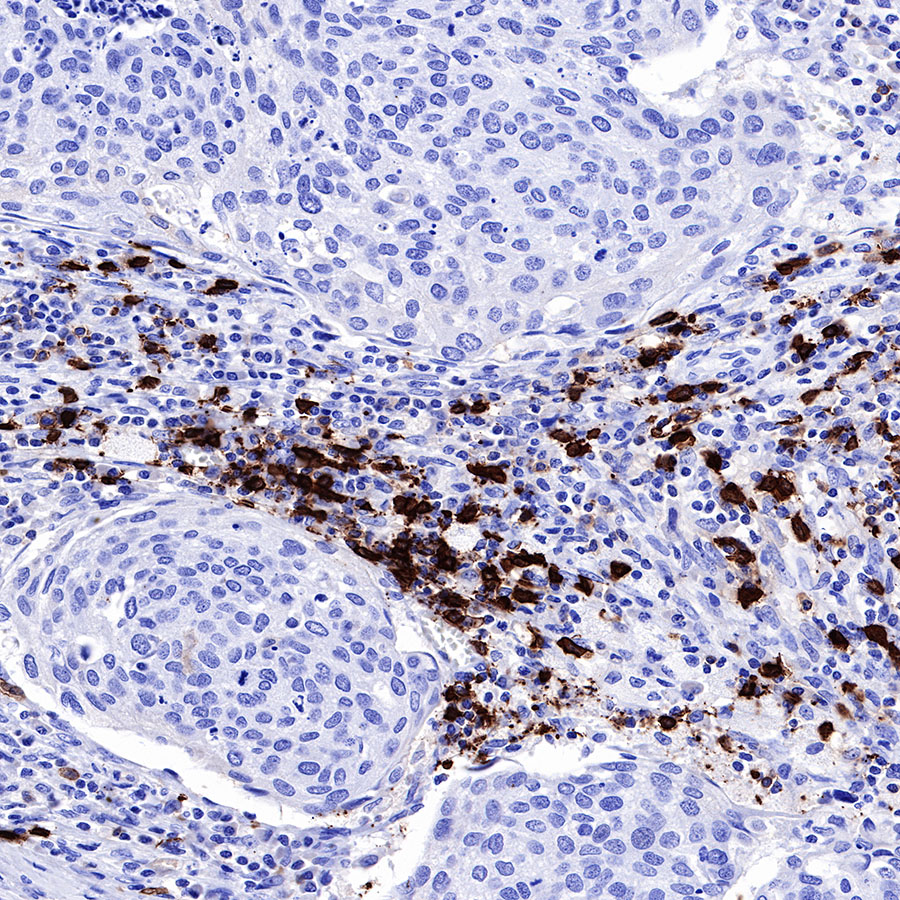
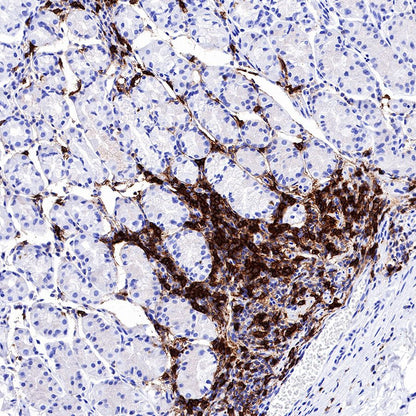
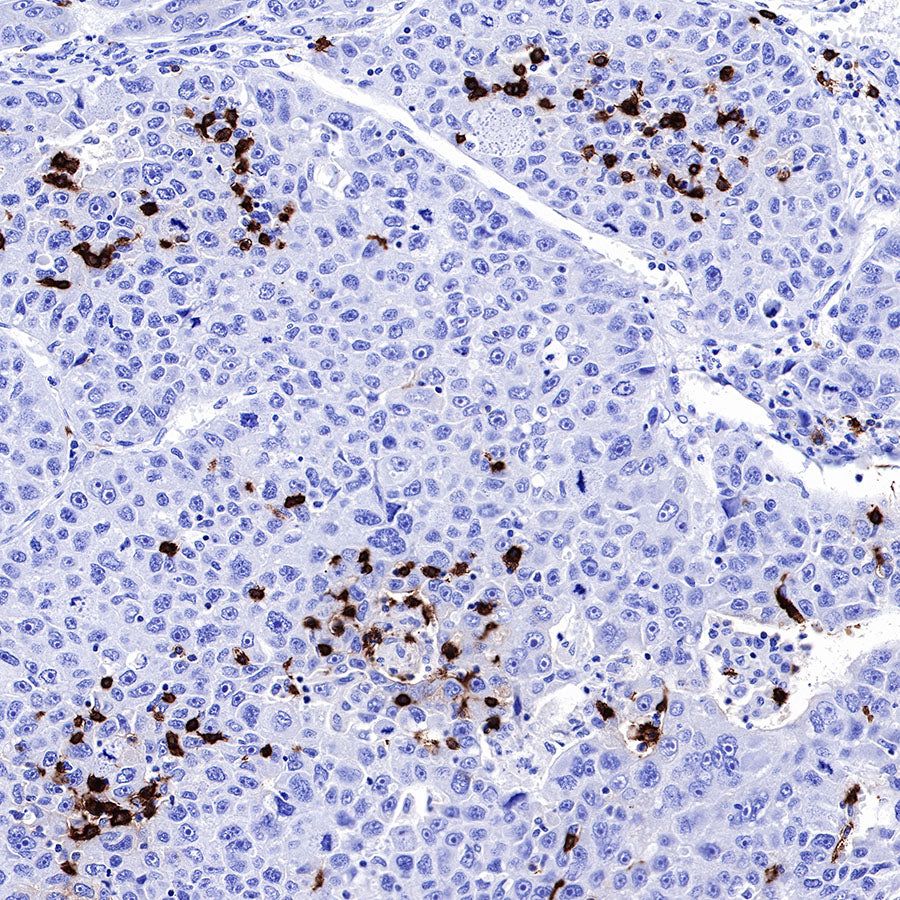

Product Details
Product Details
Product Specification
Host | Rabbit |
Antigen | CD20 |
Synonyms | B-lymphocyte antigen CD20, Bp35, Leukocyte surface antigen Leu-16, MS4A1 |
Immunogen | N/A |
Location | Cell membrane |
Accession | P11836 |
Clone Number | SDT-R133 |
Antibody Type | Rabbit mAb |
Application | WB, IHC-P, ICC |
Reactivity | Hu, Ms, Rt |
Purification | Protein A |
Concentration | 0.25 mg/ml |
Physical Appearance | Liquid |
Storage Buffer | PBS, 40% Glycerol, 0.05% BSA, 0.03% Proclin 300 |
Stability & Storage | 12 months from date of receipt / reconstitution, -20 °C as supplied |
Dilution
application | dilution | species |
WB | 1:500 | null |
IHC-P | 1:1000 | null |
ICC | 1:250 | null |
Background
The CD20 antigen is a membrane-embedded, non-glycosylated phosphoprotein, 33-37 kDa. CD20 functions as a Ca2+-permeable cation channel, involved in the regulation of B-cell activation, proliferation and differentiation. CD20 appears on the surface of the pre-B lymphocyte between the time of light chain rearrangement and expression of intact surface immunoglobulin and is lost just before terminal B-cell differentiation into plasma cells. Surface expression of CD20 on activated B cells is approximately 4-fold greater than that found on resting B cells. CD20 is virtually specific for normal B-cells. A weak expression has been demonstrated in a subpopulation of T-cells, but not in any other cell type [NordiQC].
Picture
Picture
Western Blot

Immunohistochemistry

Immunocytochemistry

ICC shows positive staining in Ramos cells. Anti-CD20 antibody was used at 1/250 dilution (Green) and incubated overnight at 4°C. Goat polyclonal Antibody to Rabbit IgG - H&L (Alexa Fluor® 488) was used as secondary antibody at 1/1000 dilution. The cells were fixed with 4%PFA and permeabilized with 0.1% PBS-Triton X-100. Nuclei were counterstained with DAPI (Blue).Counterstain with tubulin (Red).

Negative control:ICC shows negative staining in HEK293 cells. Anti-CD20 antibody was used at 1/250 dilution and incubated overnight at 4°C. Goat polyclonal Antibody to Rabbit IgG - H&L (Alexa Fluor® 488) was used as secondary antibody at 1/1000 dilution. The cells were fixed with 4%PFA and permeabilized with 0.1% PBS-Triton X-100. Nuclei were counterstained with DAPI (Blue).Counterstain with tubulin (Red).